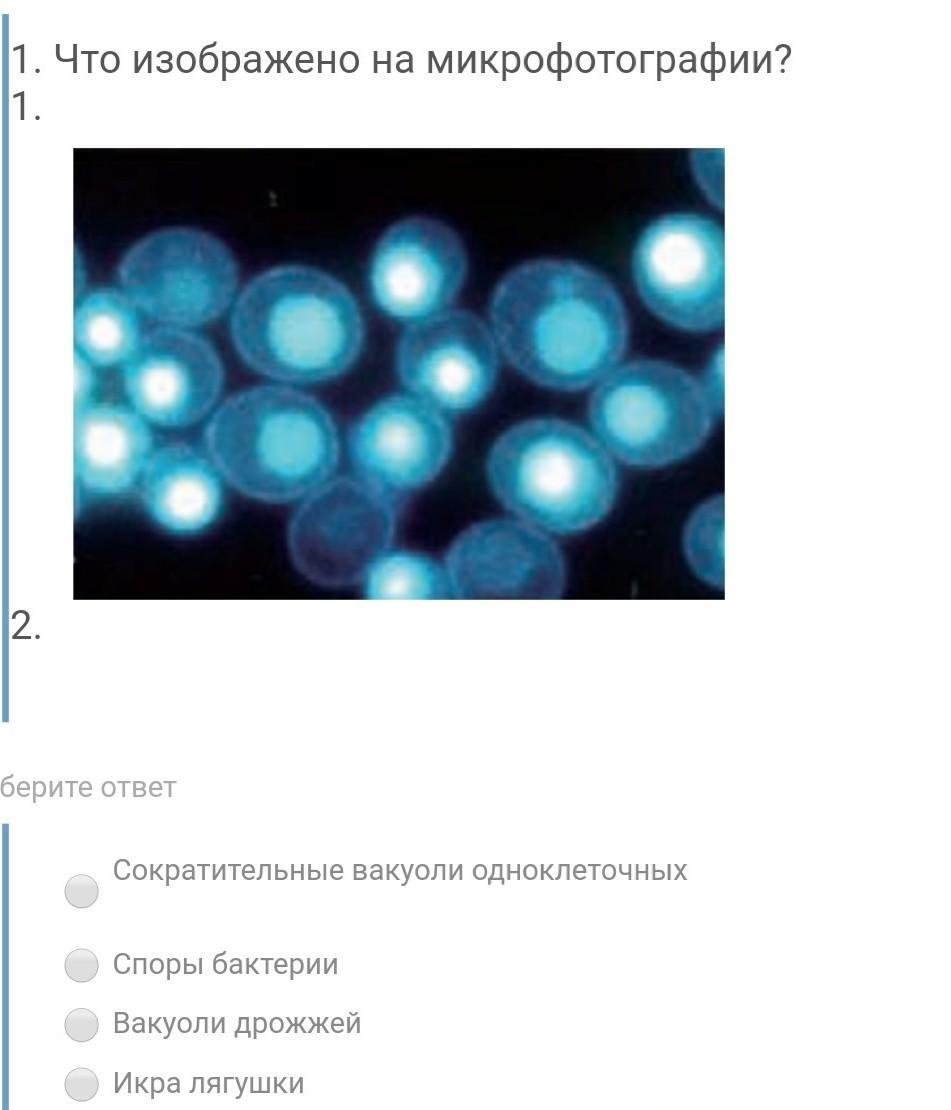

Что изображено на микрофотографии?
1)Сократительные вакуоли одноклеточных
2)Споры бактерии
3)Вакуоли дрожжей
4)Икра лягушки
Приложения:
Ответы
Ответ дал:
1
Ответ:
одноклетки )
Объяснение:
потомучто вакуола спор с .актериями оони вместе а вакуоли дрожжей и икра лягушек не совпадают
Вас заинтересует
2 года назад
2 года назад
3 года назад
3 года назад
8 лет назад
8 лет назад
9 лет назад
9 лет назад